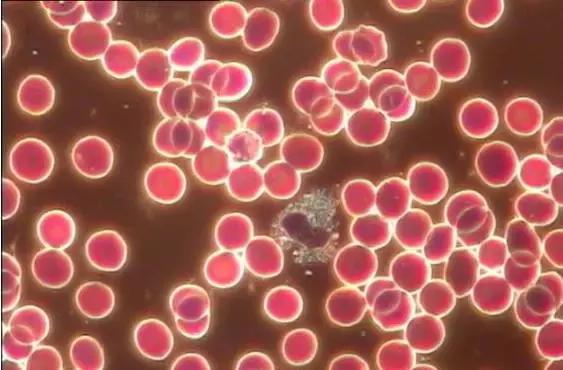
女人不来月经,身体就不能排毒吗?月经里到底有

女性不来月经是什么原因
364x284 - 10KB - JPEG

女人不来月经,身体就不能排毒吗?月经里到底有
533x399 - 25KB - JPEG

长时间不来月经的女性要小心了!你可能得了这
640x427 - 22KB - JPEG

【女人生了孩子什么时候来月经】【图】女人生
400x400 - 37KB - JPEG
女人不来月经,身体就不能排毒吗?月经里到底有
563x370 - 32KB - JPEG
【】女性月经迟迟不来的原因与食疗方|女性,月
420x278 - 20KB - JPEG

【人流后什么时候来月经】【图】人流后什么时
400x400 - 26KB - JPEG

【女人不来月经会排卵吗】_排卵_不来月经_怎
500x330 - 34KB - JPEG

女人为什么不来月经 7大原因致月经不来
484x300 - 9KB - JPEG

月经不来吃什么催经|life.yxlady.com
442x330 - 31KB - JPEG

月经迟迟不来,究竟是什么原因呢?
600x542 - 50KB - JPEG

48岁就不来月经了?绝经提前要注意
395x485 - 17KB - JPEG

【不来月经是什么原因】【图】不来月经是什么
442x331 - 27KB - JPEG

女生来例假不能吃什么,女人来例假吃什么,50岁
484x300 - 32KB - JPEG
月经推迟的原因是什么 月经推迟10天以上不来
385x220 - 9KB - JPEG
所以可以根据您第一次来月经是什么时候来加上30年推算。无意外情况下,大多数女性都是在这个时间段绝经的。
但是如果超出了这个时间,月经本正常的女性一定回担心。可分为一下四种情况:1怀孕.可在月经在月经延迟7
(3)月经周期、经量。月经周期短,经期持续天数少,经量少,无痛经的妇女一般绝经较早;月经周期长,持续
月经不来是指月经不出现的现象。西医把闭经分为原发性闭经及继发性闭经,原发性闭经中因先天生殖器官发育
你好,这位朋友,女性绝经的年龄在我国的话城市妇女平均绝经年龄49.5岁,农村内分泌紊乱都可能导致月经推
女性绝经时间一般为45-到55岁之间,一般是女性来的早走的也早,女性来的迟,应该走的也会迟,还有就是遗传
造成女性长时间不来月经的原因有很多,排除妊娠因素,还有如中枢神经系统正常月经的发生,女人不来例假的
对于有性经历的女性,月经推迟,首先要排除怀孕。若月经正常的话,可以在停经后7天后可以用早孕试纸测试,
我想知道,谁可以告诉我啊,我不想对于有性经历的女性,月经推迟,首先要排除怀孕。若月经正常的话,可以在